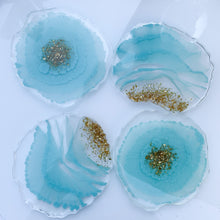
Load image into Gallery viewer, light blue handmade unique one of a kind resin coasters for holiday gift, gift for her, drink coaster, light blue flower resin coasters

Set of 4 Coasters.
Colors: Blue, gold
Size: approximately 4 - 4.5 inches across.
Made of high quality resin.
These are handmade items that may differ slightly in sizes and thickness.You may also see very small imperfections such as micro-bubbles and indentations, but it's what makes these handmade pieces unique and one-of-a-kind.
They are a great addition to any home and can be a great gift idea for any occasion!
For proper resin care instructions, please refer to the bottom of the homepage.